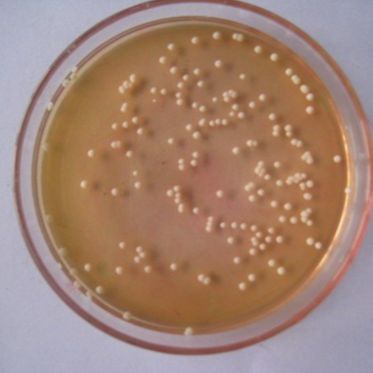
酿脓链球菌定量菌株

搜索到 27 条记录

海博HB8278 革兰氏染色液试剂盒
英文名称: Gram Stain Kit 产品货号: HB8278 产品规格: 5ml*8 产品价格: 40元 保质期: 一年 产品用途: 用于细菌的革兰氏染色试验 试剂盒组成: 组成 别名 规格 配制依据 溶液A 结晶紫染色液 5ml*2 将1.0g结晶紫完全溶解于20ml 9
文献支持品牌:海博货号:HB8278
¥40

幽门螺杆菌选择性添加剂(Dent)
, Hyclone部分常用现货。 主要经营的耗材品牌: 1. BIOHIT,单道移液半支消毒长期促销,350/支。 2. BD Fa2. BD Falcon耗材,常用常备现货。 3. BRAND,常备现货 SR0147E 幽门螺杆菌选择性添加剂(Dent) 10小瓶
品牌:OXOID货号:SR0147E
¥1167

便捷式原核微生物快速检测箱(仅供科研)
便捷式原核微生物快速检测箱(仅供科研) ★产品介绍 便捷式病原微生物检测箱(胶体 金法),属传染病控制类卫生防疫装备箱。致力于为客 户提供全面的卫生应急解决方案,专业向全疾控中心、卫生监督所、防疫站、卫生局等…… 介绍: 鼻疽菌抗原抗体检测试剂:一种能够引起鼻疽病的细菌,通过动物传
品牌:其他货号:JL1192

Ames试验菌株混合Ames Tester Strain TAMix
Unit 50 µl, liquid Description TAMix and other Ames tester strains, S. typhimurium and E. coli strains, have been used for more than 30 year
品牌:Xenometrix货号:PLI-0114
询价

黑/曲霉CMCC(F)98003(定量菌株)
9mL无菌生理盐水中,混匀。 (4)吸取上述菌液,加至待检液体培养基及计数或参比培养基中,置于适宜的条件下培养。或加至无菌空平皿中,注入15mL~20mL温度不超过46℃的已融化的待检培养基,混匀,待培养基凝固后,用5mL培养基覆盖,凝固后倒置培养。 hei曲霉CMCC(F)980
品牌:青岛海博生物货号:HBJZDL112/HBJZDL112-1

大肠杆菌Nissle 1917,SHBCC D24669,DSM 6601
菌种名:大肠杆菌Nissle 1917 拉丁名: 菌种编号:SHBCC D24669 其他编号:DSM 6601 模式菌株: 主要用途:科研 具体用途:益生菌 生物危害程度:四级 培养基名称:LB培养基 培养基成分:蛋白胨 10g,酵母粉 5g,氯化钠 10g,pH7.2-7.4
品牌:上海保藏生物技术中心SHBCC货号:SHBCC D24669

甲型溶血性链球菌
基本信息 资源编号 BNCC102663 资源名称 甲型溶血性链球菌 种属 Streptococcus hemolytis-α 分离基物 来源于卫生部检定所,分离自慢性气管炎患者。 提供形式 冻干物 致病类型 致病对象:人 安全等级 2 模式菌株 no 应用领域 研究;教学;分类
品牌:BNCC货号:BNCC102663
询价

MCE (MedChemExpress)生物活性化合物-信号通路-抗感染-Parasite (寄生虫)-11
寄生虫表现出纳摩尔级效力,对哺乳动物 DHODH 没有抑制作用。DSM705 是一种有效的抗疟化合物。 HY-D0143A Quinine dihydrochloride 奎宁二 酸盐 Inhibitor Quinine dihydrochloride 是一种从金鸡纳树皮中提取的
品牌:MCE (MedChemExpress)生物活性化合物-信号通路-抗感染-Parasite (寄生虫)货号:目录号: HY-14932

pENTR223-THUMPD3(3同义突变)
[名称首字母] P [载体宿主] 大肠杆菌 [基因类型] cDNA [原核抗性] Spe 别称: NM_001114092.1 复制子: pUC 原核抗性: Spe 克隆菌株: DH5a 培养条件: 37度 质粒属性 载体宿主: 大肠杆菌 载体用途: PCR模板 基因种属: 人
品牌:智立中特货号:zl-029109

MicroSwabPlus定性菌株
MicroSwabPlus定性菌株 定性菌株产品,来源于美国ATCC菌种保藏所。适用于无定量要求的客户。 品牌: MECCONTI 类别: 定性菌株 用途: 微生物检测 产品编号: MicroSwabPlus 计量单位: MicroSwabPlus定性菌株 定性菌株产品,来源于美
文献支持品牌:MECCONTI货号:MicroSwabPlus
¥1

三糖铁琼脂(TSI)
三糖铁琼脂(TSI) 英文名称:TSI Agar 生化培养基,用于肠杆菌科细菌的生化反应筛选(GB标准) 成分(g/L): 蛋白胨 20.0 牛肉浸粉 5.0 氯化钠 5.0 乳糖 10.0 葡萄糖 1.0 蔗糖 10.0 酚红 0.025 硫酸亚铁胺 0.2 硫代硫酸钠 0.2
品牌:Xkbio货号:XK-P0305
酿脓链球菌定量菌株
酿脓链球菌定量菌株微生物的生长伴随着一系列生理指标发生变化,与生长量相平行的生理指标很多,它们可作为生长测定的相对值。1、测定含氮量:大多数细菌的含氮量为干重的12.5%,酵母为7.5%,霉菌为6.0%。根据含氮量×6.25,即可测定粗蛋白的含量。含氮量的测定方法有很多2、测定含碳
品牌:晶风生物货号:GF372973

微球菌粉
微球菌粉产品优点如下: 1、快速简便:全程约50分钟,可测100例左右样本。 2、取样量微:本法取样本量100ul。 3、稳定性好:试剂盒2~8℃存放6个月有效。 4、再现性好:变异系数CV=1.7%。 5、回收试验: X =103.3%。 6、受外界影响因素小:干扰因素少,重复
品牌:上海雅吉生物科技有限公司货号:A050-2

SG/-His/-Trp/-Ura平板(φ9 cm,含半乳糖)
中文名称:SG/-His/-Trp/-Ura平板(φ9 cm,含半乳糖) 英文名称:SG/-His/-Trp/-Ura Plates(φ9 cm,with Gal) 产品规格:10块 发货周期:1~3天 产品价格:询价 货号 规格 发货期 用途 LZ-PYJ4695 10块 1~
品牌:联祖货号:LZ-PYJ4695
¥600

DB3.1大肠杆菌克隆菌
基因克隆 备注: 菌株简介: DB3.1属于大肠杆菌克隆型菌种,DB3.1大肠杆菌菌株基因组中含有 gyrA462 基因,赋予其对λ嗜菌体的ccdB毒性基因的抗性,特别适用于构建或扩繁含有ccdB基因的质粒载体(例如GATEWAY System Vector) ,此菌株具有链霉素抗
品牌:KLSW货号:KL-J-0108

生活饮用水中菌落总数质控样(冻干菌粉)
生活饮用水中菌落总数质控样(冻干菌粉) 【产品名称】 :生活饮用水中菌落总数质控样 【产品规格】 :2支/盒 【储存条件】:-20℃密封避光 【有效期】:具体以标签为准 【产品描述】: 冻干菌粉,含保护剂,外观为松散状白色粉末,6mL西林瓶真空包装。 本产品仅供科研实验用,不做其
品牌:信帆生物货号:XFB0642

DO Supplement -His/-Trp
DO Supplement -His/-Trp 中文名:DO Supplement -His/-Trp 英文名:DO Supplement -His/-Trp CAS:N/A 级别:N/A 分子量:N/A 分子式:N/A 纯度:N/A 储存条件:2-8℃ 产品简介 DO Supp
品牌:泽叶生物货号:ZY2280-20g
¥598

杀鲑气单胞菌日本鲑亚种
杀鲑气单胞菌日本鲑亚种 菌种 菌种驯化,诱变,发酵工艺优化等. 1.驯化:提供生长培养基以及驯化培养基,说明定向驯化预期目标以及其他相关事项. 2.诱变:提供生长培养基以及诱变培养基,说明诱变形式,预期目标以及其他相关事项. 3.发酵优化:提供生长培养基,需要优化发酵参数,说明诱
品牌:ATCC货号:ATCC27013
¥380-1960
相关热门产品






